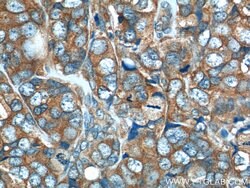
GAB2 Rabbit anti-Human, Mouse, Polyclonal, Proteintech 20 &mu;L; Unconjugated:Antibodies,
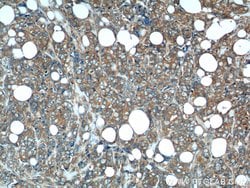
GAB2 Rabbit anti-Human, Mouse, Polyclonal, Proteintech 20 &mu;L; Unconjugated:Antibodies,

missing translation for 'onlineSavingsMsg'
Learn More
Learn More
GAB2 Rabbit anti-Human, Mouse, Polyclonal, Proteintech
Rabbit Polyclonal Antibody
Brand: Proteintech 22549-1-AP-20UL
This item is not returnable.
View return policy
Description
This gene is a member of the GRB2-associated binding protein (GAB) gene family and is similar to the GAB1 gene. These proteins contain pleckstrin homology (PH) domain, and bind SHP2 tyrosine phosphatase and GRB2 adapter protein. They act as adapters for transmitting various signals in response to stimuli through cytokine and growth factor receptors, and T- and B-cell antigen receptors. The protein encoded by this gene is the principal activator of phosphatidylinositol-3 kinase in response to activation of the high affinity IgE receptor. Two alternatively spliced transcripts encoding different isoforms have been described for this gene.Specifications
| GAB2 | |
| Polyclonal | |
| Unconjugated | |
| GAB2 | |
| GAB2, GRB2 associated binder 2, KIAA0571, pp100 | |
| Rabbit | |
| Antigen Affinity Chromatography | |
| RUO | |
| 14389, 9846 | |
| -20°C | |
| Liquid |
| Immunocytochemistry, Immunofluorescence, Immunohistochemistry (Paraffin), Western Blot | |
| 0.17 mg/mL | |
| PBS with 50% glycerol and 0.02% sodium azide; pH 7.3 | |
| Q9UQC2, Q9Z1S8 | |
| GAB2 | |
| GAB2 Fusion Protein Ag18192 | |
| 20 μL | |
| Primary | |
| Mouse, Human | |
| Antibody | |
| IgG |
Product Content Correction
Your input is important to us. Please complete this form to provide feedback related to the content on this product.
Product Title
Vous avez repéré une opportunité d'amélioration ?Partager une correction de contenu